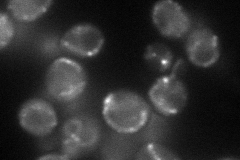
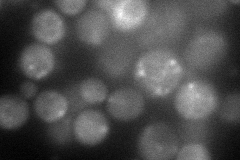
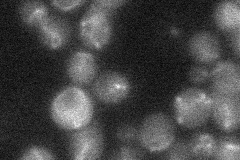
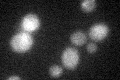
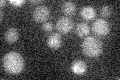

View description
Peripheral protein of the cytosolic face of the mitochondrial outer membrane, required for mitochondrial fission; interacts with Fis1p and with the dynamin-related GTPase Dnm1p; contains WD repeats
Localization:
Intensity:
Fold change:
Significance:
-
C’ GFP library in SD

below threshold16.28 -
N' NOP1pr-GFP in SD
punctate,mitochondria51.9378 -
N' TEF2pr-mCherry in SD
punctate69.9508 -
N' NATIVEpr-GFP in SD
mitochondria19.8112 -
N' TEF2pr-VC and Cyto-VN in SD

punctate38.217 -
C’ GFP library in SD+DTT
cytosol13.650.83No -
C’ GFP library in SD+H2O2

cytosol15.520.95No -
C’ GFP library in Starvation Media
cytosol14.290.87No -
C’ GFP library on the background of Pup2-DaMP

below threshold -
C’ GFP library on the background of CCT mutant

below threshold15.60770.958014No
